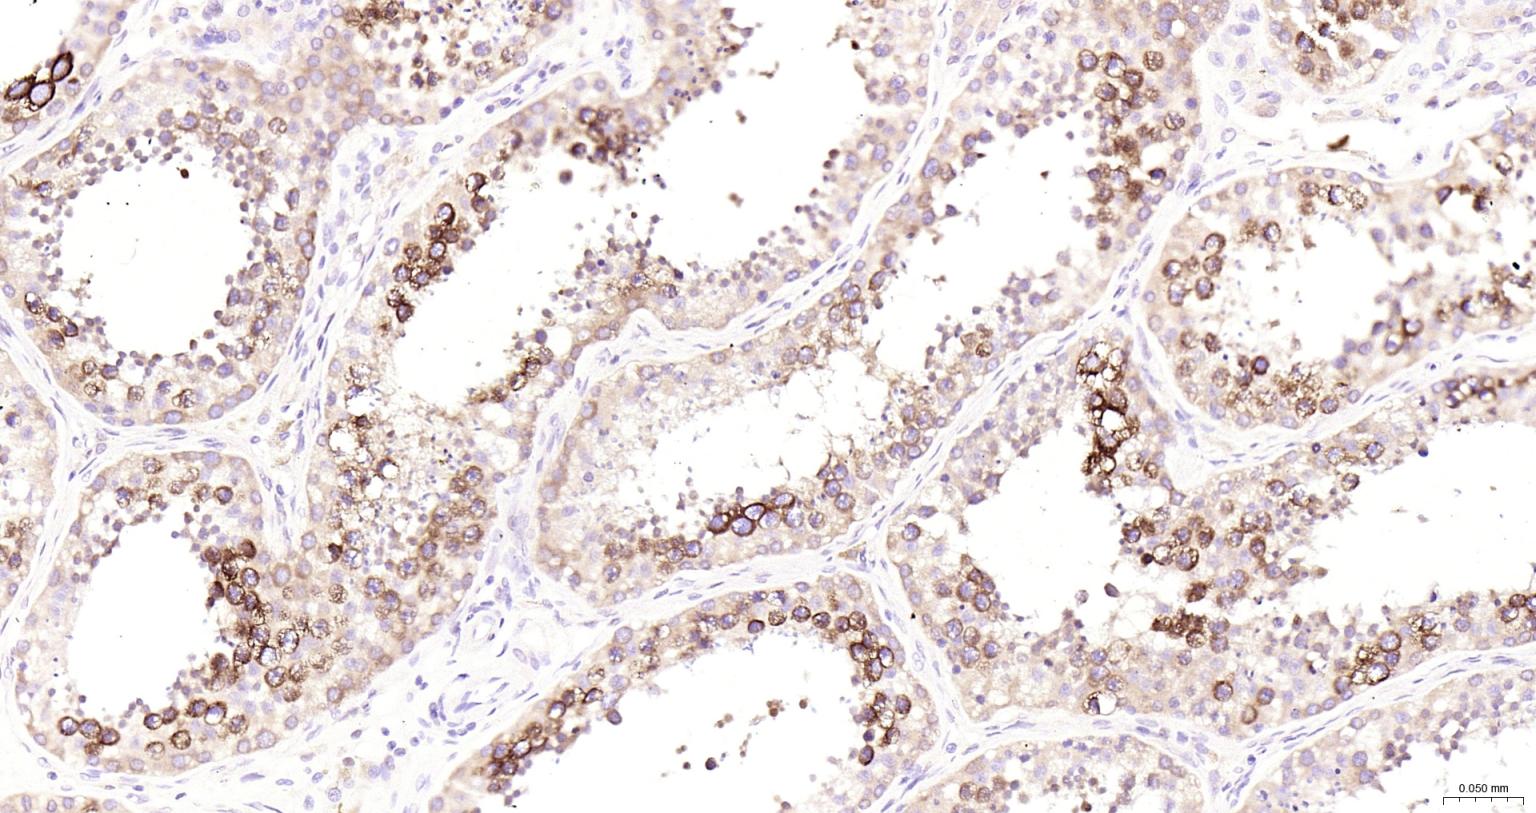
组蛋白去乙酰化酶6抗体-bs-2811R

HDAC6 Rabbit pAb (一抗) - WB,IHC-P,IHC-F,IF,ICC/IF | Bioss

货号:bs-2811R
产品详情
相关标记
相关产品
相关文献
常见问题
概述
产品编号
bs-2811R
产品类型
农牧业/家禽抗体
英文名称
HDAC6 Rabbit pAb
中文名称
组蛋白去乙酰化酶6抗体
英文别名
CPBHM; HD6; JM21; KDAC6; PPP1R90; Hdac5; Sfc6; mHDA2; HDAC6_HUMAN; HDAC6; E3 ubiquitin-protein ligase HDAC6; Tubulin-lysine deacetylase HDAC6; 3.5.1.-; KIAA0901; HDAC6_MOUSE; histone deacetylase 6; protein phosphatase 1, regulatory subunit 90; alpha-tubulin deacetylase HDAC6
抗体来源
Rabbit
免疫原
KLH conjugated synthetic peptide derived from human HDAC6: 301-400/1215
亚型
IgG
性状
Liquid
纯化方法
affinity purified by Protein A
克隆类型
Polyclonal
理论分子量
134 kDa
检测分子量
134 kDa
浓度
1mg/ml
储存液
0.01M TBS (pH7.4) with 1% BSA, 0.02% Proclin300 and 50% Glycerol.
研究领域
SWISS
Gene ID
保存条件
Shipped at 4℃. Store at -20℃ for one year. Avoid repeated freeze/thaw cycles.
注意事项
This product as supplied is intended for research use only, not for use in human, therapeutic or diagnostic applications.
数据库链接
产品介绍
HDAC6是一种比较独特的组蛋白去乙酰化酶,含有两个功能上相互独立的HDAC催化结构域。HDAC6可以去乙酰化组蛋白并抑制相关基因转录。
HDAC6可以和微管(microtuble)结合,可以去乙酰化tubulin,Hsp90和cortactin等。目前发现大量的蛋白可以被乙酰化修饰,因此HDAC等乙酰化修饰酶被认为在基因转录调控、信号转导、生长发育、分化凋亡、代谢性疾病和肿瘤等多种生理病理过程中发挥重要作用。HDAC的抑制剂目前被认为是很有前景的肿瘤治疗药物。
内源性HDAC6主要定位于细胞浆,与微管相结合并且是一个微管蛋白去乙酰化酶。HDAC6含有一个锌指结构域,该结构域可能和泛素化降解的调节有关。HDAC6可以和DHAC11相互作用。
HDAC6可以和微管(microtuble)结合,可以去乙酰化tubulin,Hsp90和cortactin等。目前发现大量的蛋白可以被乙酰化修饰,因此HDAC等乙酰化修饰酶被认为在基因转录调控、信号转导、生长发育、分化凋亡、代谢性疾病和肿瘤等多种生理病理过程中发挥重要作用。HDAC的抑制剂目前被认为是很有前景的肿瘤治疗药物。
内源性HDAC6主要定位于细胞浆,与微管相结合并且是一个微管蛋白去乙酰化酶。HDAC6含有一个锌指结构域,该结构域可能和泛素化降解的调节有关。HDAC6可以和DHAC11相互作用。
背景资料
HDAC6 is a member of the class II mammalian histone deacetylases. Human HDAC6 is composed of 1215 amino acid residues. It possesses two separate putative catalytic domains. Both catalytic domains are fully functional HDACs and contribute independently to the overall activity of HDAC6 protein. A very potent NES is present at the amino-terminus of HDAC6, which was found to play an important role in regulating the shuttling of HDAC6 protein between cytoplasm and nucleus. The shuttling process may be a critical regulatory mechanism of HDAC6 function. The expression of HDAC6 is tightly linked to the state of cell differentiation. HDAC6 may participate in coordinating expression of a group of genes involved in the remodelling of chromatin during cell differentiation.

产品应用
| 应用 | 已检合格种属 | 预测种属 | 推荐稀释比例 |
|---|---|---|---|
| WB | Human | 1:500-2000 | |
| IHC-P | Human | 1:100-500 | |
| IHC-F | Human | 1:100-500 | |
| IF | Human | 1:100-500 | |
| ICC/IF | Human | 1:50-200 |
交叉反应
交叉反应: Human
相关产品
暂无相关产品
靶标
基因名
HDAC6
蛋白名
Histone deacetylase 6
亚基
Interacts with CBFA2T3, HDAC11 and SIRT2. Interacts with F-actin. Interacts with BBIP10. Under proteasome impairment conditions, interacts with UBD via its histone deacetylase 1 and UBP-type zinc-finger regions. Interacts with CYLD. Interacts with ZMYND15 (By similarity). Interacts with DDIT3/CHOP.
亚细胞定位
Nucleus. Cytoplasm. Note=It is mainly cytoplasmic, where it is associated with microtubules.
翻译后修饰
Phosphorylated by AURKA.
Ubiquitinated. Its polyubiquitination however does not lead to its degradation.
Sumoylated in vitro.
Ubiquitinated. Its polyubiquitination however does not lead to its degradation.
Sumoylated in vitro.
相似性
Belongs to the histone deacetylase family. HD type 2 subfamily.
Contains 1 UBP-type zinc finger.
Contains 1 UBP-type zinc finger.
功能
Responsible for the deacetylation of lysine residues on the N-terminal part of the core histones (H2A, H2B, H3 and H4). Histone deacetylation gives a tag for epigenetic repression and plays an important role in transcriptional regulation, cell cycle progression and developmental events. Histone deacetylases act via the formation of large multiprotein complexes. Plays a central role in microtubule-dependent cell motility via deacetylation of tubulin.
In addition to its protein deacetylase activity, plays a key role in the degradation of misfolded proteins: when misfolded proteins are too abundant to be degraded by the chaperone refolding system and the ubiquitin-proteasome, mediates the transport of misfolded proteins to a cytoplasmic juxtanuclear structure called aggresome. Probably acts as an adapter that recognizes polyubiquitinated misfolded proteins and target them to the aggresome, facilitating their clearance by autophagy.
In addition to its protein deacetylase activity, plays a key role in the degradation of misfolded proteins: when misfolded proteins are too abundant to be degraded by the chaperone refolding system and the ubiquitin-proteasome, mediates the transport of misfolded proteins to a cytoplasmic juxtanuclear structure called aggresome. Probably acts as an adapter that recognizes polyubiquitinated misfolded proteins and target them to the aggresome, facilitating their clearance by autophagy.
同靶标产品
相关文献
提示: 发表研究结果有使用 bs-2811R 时请让我们知道,以便我们可以引用参考文章。作为回馈,资料提供者将获得我们送上的小礼品。
具体参考文献:bs-2811R 被引用于5文献中